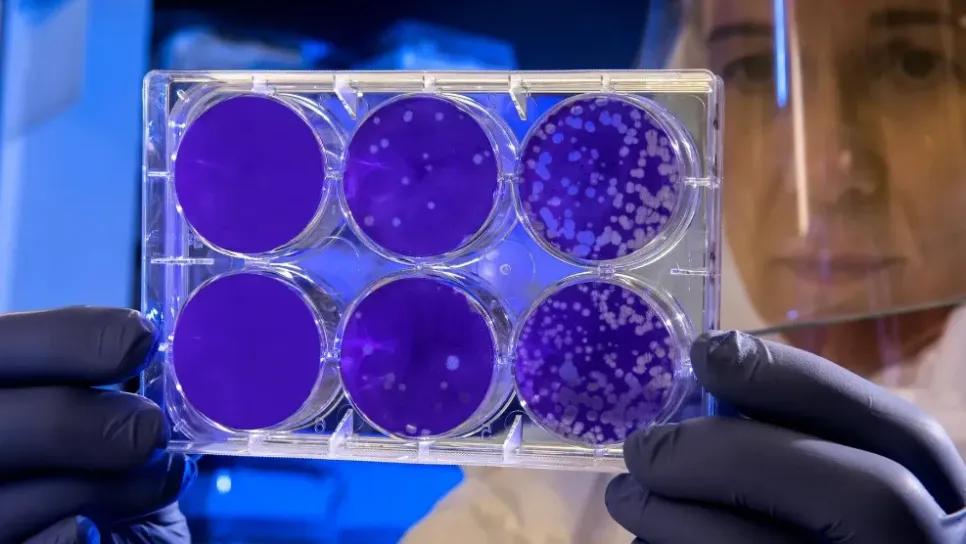

تعتبر "الدفتيريا" عدوى تسببها بكتيريا الخُنَّاق الوتدية، وعادةً ما تبدأ علاماتها وأعراضها بعد يومين إلى خمسة أيام من التعرّض للبكتيريا المسببة لها وتتراوح حدتهما بين خفيفة ووخيمة. وقالت منظمة الصحة العالمية أنه غالباً ما تظهر الأعراض تدريجياً وتبدأ بالتهاب في الحلق وحمى. وفي الحالات الوخيمة، تُنتج هذه البكتيريا سُمّاً (ذِيفاناً) يُحدث لَطْخة سميكة رمادية أو بيضاء اللون في مؤخرة الحلق. ويمكن لهذه اللطخة أن تسدّ مجرى الهواء فيصعب التنفس أو البلع، كما يمكن أن تسبب سُعالاً نُباحياً. وقد يتورّم العُنق لأسباب منها تضخّم العقد اللمفية. وينتشر وباء "الدفتيريا" بين الأشخاص بالملامسة المباشرة أو استنش...
مقال مؤرشفهذا المقال مخصص للمشتركين
انضموا إلينا للوصول إلى هذا المقال وجميع المحتويات، لا تفوتوا المعلومات التي تهمكم.
لديك حساب ؟ تسجيل الدخول

التعليقات
شارك تسجيل الدخول
الخروج
التعليقات مغلقة لهذا المقال